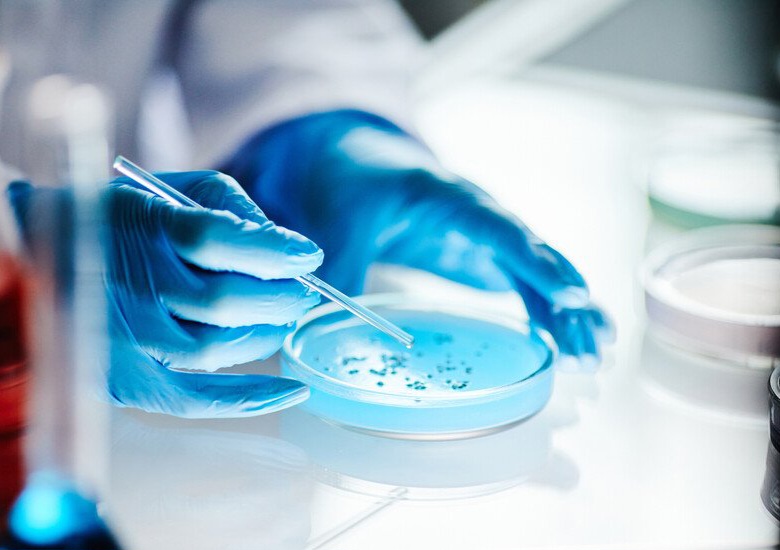

كشف باحثون في المركز الإسباني لأبحاث السرطان عن آلية بيولوجية غير متوقعة تتحكم في البلوغ والخصوبة، بعد اكتشاف دور مهم لخلايا مناعية في الدماغ إلى جانب بروتين معروف سابقاً بوظيفته في صحة العظام.
وأوضحت دراسة نُشرت في مجلة Science أن ما يُعرف بـ"الخلايا الدبقية الصغيرة" (Microglia)، وهي خلايا مناعية تعمل كخط دفاع للجهاز العصبي، تلعب دوراً أساسياً في تنظيم الخلايا العصبية المسؤولة عن الخصوبة من خلال بروتين يسمى RANK.
وقادت الدراسة الباحثة إيفا غونزاليس-سواريز، التي أشارت إلى أن اكتشاف دور خلايا مناعية في تنظيم الخصوبة بدلاً من الخلايا العصبية يمثل تطوراً علمياً مهماً قد يفتح آفاقاً جديدة لفهم آليات البلوغ.
وبيّنت التجارب التي أُجريت على الحيوانات أن تعطيل بروتين RANK قبل مرحلة البلوغ يمنع الوصول إلى النضج الجنسي ويؤدي إلى انخفاض حاد في الهرمونات الجنسية، بينما يؤدي تعطيله لدى الحيوانات البالغة إلى العقم الكامل خلال فترة قصيرة.
كما امتدت الدراسة إلى تحليل عينات بشرية من مرضى يعانون من متلازمة نادرة تُعرف باسم قصور الغدد التناسلية النخامي الخلقي، حيث اكتشف الباحثون وجود طفرات في الجين المسؤول عن إنتاج هذا البروتين لدى بعض المرضى.
ويرى العلماء أن هذا الاكتشاف قد يفتح الباب أمام تطوير علاجات جديدة لبعض حالات العقم واضطرابات البلوغ، فضلاً عن إمكانية استخدام بروتين RANK كمؤشر جيني لتشخيص حالات العقم غير المعروفة الأسباب.
وأشار الباحث الرئيسي في الدراسة أليخاندرو كويادو إلى أن هذا الإنجاز جاء نتيجة تعاون بين تخصصات علمية متعددة، ما أتاح التوصل إلى نتائج غير متوقعة قد تسهم في فهم وظائف أخرى في الدماغ مثل تنظيم الشهية والاستجابة للإجهاد.
م.ال

اضف تعليق